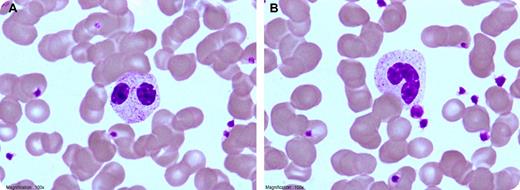
The peripheral smear of a 35-year-old man showed 47% bilobed neutrophils (panel A) and 45% band forms (panel B). A diagnosis of Pelger-Huet anomaly was considered. When a similar smear, seen earlier in a 3-year-old boy was remembered, it was learned that the patients were father and son. A diagnosis of congenital Pelger-Huet was affirmed. / Pelger-Huet anomaly is a rare autosomal dominant disorder characterized by pince-nez appearance of the nuclei of the neutrophils. This is caused by failure of nuclear segmentation due to genetic defect in the LBR (laminin B-receptor) on the chromosome 1q41-43. Heterozygotes have dumbbell-shaped or hyposegmented neutrophils with coarse chromatin and normal granules. Homozygotes have neutrophils with a single, round, eccentric nucleus with clumped chromatin and no nuclear segmentation. It is important to recognize Pelger-Huet anomaly as a benign condition. An acquired abnormality is referred to as pseudo Pelger-Huet anomaly. This may occur in myelodysplastic disorders, myeloproliferative diseases, and acute and chronic leukemias, reactions to drugs, and so on. The history and peripheral smear make the differential between congenital Pelger-Huet and acquired.

The peripheral smear of a 35-year-old man showed 47% bilobed neutrophils (panel A) and 45% band forms (panel B). A diagnosis of Pelger-Huet anomaly was considered. When a similar smear, seen earlier in a 3-year-old boy was remembered, it was learned that the patients were father and son. A diagnosis of congenital Pelger-Huet was affirmed.
Pelger-Huet anomaly is a rare autosomal dominant disorder characterized by pince-nez appearance of the nuclei of the neutrophils. This is caused by failure of nuclear segmentation due to genetic defect in the LBR (laminin B-receptor) on the chromosome 1q41-43. Heterozygotes have dumbbell-shaped or hyposegmented neutrophils with coarse chromatin and normal granules. Homozygotes have neutrophils with a single, round, eccentric nucleus with clumped chromatin and no nuclear segmentation. It is important to recognize Pelger-Huet anomaly as a benign condition. An acquired abnormality is referred to as pseudo Pelger-Huet anomaly. This may occur in myelodysplastic disorders, myeloproliferative diseases, and acute and chronic leukemias, reactions to drugs, and so on. The history and peripheral smear make the differential between congenital Pelger-Huet and acquired.
The peripheral smear of a 35-year-old man showed 47% bilobed neutrophils (panel A) and 45% band forms (panel B). A diagnosis of Pelger-Huet anomaly was considered. When a similar smear, seen earlier in a 3-year-old boy was remembered, it was learned that the patients were father and son. A diagnosis of congenital Pelger-Huet was affirmed.
Pelger-Huet anomaly is a rare autosomal dominant disorder characterized by pince-nez appearance of the nuclei of the neutrophils. This is caused by failure of nuclear segmentation due to genetic defect in the LBR (laminin B-receptor) on the chromosome 1q41-43. Heterozygotes have dumbbell-shaped or hyposegmented neutrophils with coarse chromatin and normal granules. Homozygotes have neutrophils with a single, round, eccentric nucleus with clumped chromatin and no nuclear segmentation. It is important to recognize Pelger-Huet anomaly as a benign condition. An acquired abnormality is referred to as pseudo Pelger-Huet anomaly. This may occur in myelodysplastic disorders, myeloproliferative diseases, and acute and chronic leukemias, reactions to drugs, and so on. The history and peripheral smear make the differential between congenital Pelger-Huet and acquired.
For additional images, visit the ASH IMAGE BANK, a reference and teaching tool that iscontinually updated with new atlas and case study images. For more information visit http://imagebank.hematology.org.
This feature is available to Subscribers Only
Sign In or Create an Account Close Modal